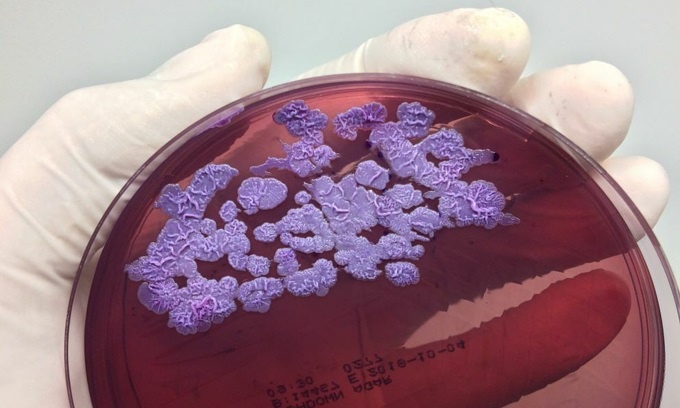

Mỗi buổi sáng, Prasart Songsorn (Thái Lan) thường thức dậy trước bình minh và làm công việc quen thuộc của mình: cấy lúa, chăm sóc ruộng đồng. Cuộc sống của người đàn ông 56 tuổi gắn chặt với những mảnh đất màu mỡ, với mặt trời nhiệt đới và không khí ẩm ngột ngạt. Trong từng ấy năm, ông chưa từng một lần đeo giày hay ủng khi làm công việc quen thuộc.
Mặc dù được chẩn đoán mắc tiểu đường năm 40 tuổi, Songorn dường như không thấy vấn đề gì đáng lo ngại. Nhiều chục năm gắn bó với đồng ruộng, ông chưa nghỉ một ngày làm việc nào. Đầu tháng 6/2017, cơn khó thở kèm sốt cao ập đến. Songorn cũng giống nhiều người nông dân khác, đều không bận tâm quá nhiều và cho rằng đó là triệu chứng cảm sốt thông thường.
 |
| Whitmore sống trong lòng đất, vì vậy những người dân gắn bó với ruộng đồng có nguy cơ mắc bệnh cao. Ảnh: Karl Joel Larsson. |
Cho đến khi căn bệnh trở nặng, người đàn ông 56 tuổi mới đến trạm xá địa phương và được chẩn đoán là biến chứng tới thận do tiểu đường. Các bác sĩ chuyển ông tới Bệnh viện Nakhasithiprasong (Ubon Ratchathani, Thái Lan).
Em gái của Songorn, bà Aroon, nghi ngờ vào kết quả này. Khó có thể tưởng tượng được khó thở lại liên quan đến thận. Người đàn ông xấu số đã qua đời mà không hề hay biết mình mắc bệnh melioidosis hay còn gọi là Whitmore. Đây là một trong những nguyên nhân hàng đầu gây nên viêm phổi ở Ubon Ratchathani (Thái Lan), nhất là trong mùa mưa nhưng nó vẫn là ẩn số với loài người.
“Chúng tôi chưa bao giờ nghe nói về bệnh melioidosis. Sau khi em tôi chết, mọi người nhận được tập tài liệu nói rằng nguyên nhân là chính mảnh đất cày cấy mỗi ngày. Các bác sĩ còn chỉ dẫn cách phòng bệnh”, anh trai của Songsorn nói.
Whitmore nguy hiểm thế nào?
Từ năm 2002, TS Direk Limmathurotsakul đã bắt đầu nghiên cứu về Whitmore tại Viện nghiên cứu y học nhiệt đới Mahidol Oxford (Moru, Bangkok). Khi đó, tỷ lệ mắc bệnh rất thấp khiến WHO liệt kê Whitmore vào nhóm không rõ lai lịch.
Whitmore do vi khuẩn Burkholderia pseudomallei gây nên. Người bệnh sẽ gặp hàng loạt triệu chứng như sốt, đau cơ, ho và áp xe một số bộ phận. Những biểu hiện này không đặc trưng nên thường khiến người bệnh chủ quan.
 |
| Bàn chân phải của bệnh nhân lở, loét - đây là vị trí được nghi ngờ là điểm tiếp xúc khiến vi khuẩn Burkholderia Pseudomallei xâm nhập vào cơ thể người bệnh. Ảnh: Bệnh viện Đa khoa Hà Tĩnh. |
Người đầu tiên phát hiện đại dịch này là bác sĩ người Anh Alfred Whitmore và trợ lý phẫu thuật Krishnaswami vào những năm 1910. Họ nhận thấy điểm chung trong một nhóm bệnh nhân tại Bệnh viện Đa khoa Rangoon ở Myanmar (ngày nay là thành phố Yangon. Myanmar). Đó là nhóm thanh niên hoàn toàn bình thường, tử vong sau những cơn sốt, vết phồng rộp và các dấu vết của việc tiêm thuốc phiện. Ban đầu, Alfred Whitmore nghi ngờ ma túy là nguyên nhân gây ra cái chết cho các nạn nhân. Tuy nhiên, vị trí các vết áp xe khiến ông suy nghĩ lại.
Họ nghiên cứu và đặt tên cho vi khuẩn gây bệnh là Bacillus pseudomallei nhưng không thể tìm ra kháng sinh điều trị. Năm 1932, căn bệnh chính được được gọi với cái tên là melioidosis. Các vi khuẩn gây bệnh được tìm thấy trong đất, nước trên khắp Đông Nam Á và chủ yếu ở Thái Lan, Myanmar, Campuchia, Lào.
Tỷ lệ tử vong cao, chưa có thuốc đặc trị
Năm 1927, ca mắc Whitmore đầu tiên được phát hiện tại Sri Lanka. Ban đầu, các bác sĩ điều trị bệnh bằng lửa, sau đó là kháng sinh. Nhưng kết quả vẫn rất thảm khốc: 50% bệnh nhân tử vong sau khi phát hiện mắc bệnh.
Từ tháng 7 đến tháng 10, những cơn mưa xối xả khuấy động vi khuẩn ngủ sâu trong lòng đất. Những người nông dân trồng lúa như Songorn đầm mình trên cánh đồng, tay chân họ tiếp xúc với vi khuẩn và không hề biết hay biết. Trong năm mà Songorn qua đời, hơn 100 người tại Nakhasithiprasong đã chết vì nguyên nhân tương tự.
|
| Đến nay, các nhà khoa học chưa tìm ra cách điều trị Whitmore. Tỷ lệ tử vong vì bệnh xấp xỉ 50%. Ảnh: Shutter. |
Tỷ lệ tử vong do bệnh Whitmore ở Thái Lan dao động ở mức 50%. Ở miền bắc Australia, ít nhất 10-20% bệnh nhân không qua khỏi. Trong khi tỷ lệ tử vong của bệnh sốt rét là 0,2%, sốt xuất huyết 1%.
Năm 1932, 83 trường hợp đã được báo cáo ở Nam và Đông Nam Á với tỷ lệ tử vong 98%. WHO ước tính có 165.000 người bị nhiễm vi khuẩn này vào năm 2015 và 89.000 người đã chết.
GS Bart Currie, Trường Nghiên cứu Sức khỏe Menzies (Australia) cho biết một xu hướng đáng lo ngại là bệnh tiểu đường đang gia tăng ở các nước đang phát triển. Trong khi đó, những người mắc bệnh tiểu đường có nguy cơ mắc melioidosis cao hơn.
Để phòng tránh Whitmore, người dân nên lưu ý những điểm sau:
- Sử dụng phương tiện bảo hộ khi lao động, nhất là những người phải tiếp xúc trực tiếp với môi trường đất và nước
- Giữ vệ sinh sạch sẽ, rửa sạch tay chân bằng xà phòng sau khi tiếp xúc với nguồn đất
- Ở những vùng bệnh Whitmore đang hoành hành, tuyệt đối tránh tiếp xúc trực tiếp với đất và nước bị ô nhiễm, nhất là khu vực trang trại
- Không chủ quan với các triệu chứng như khó thở, sốt, áp-xe…


